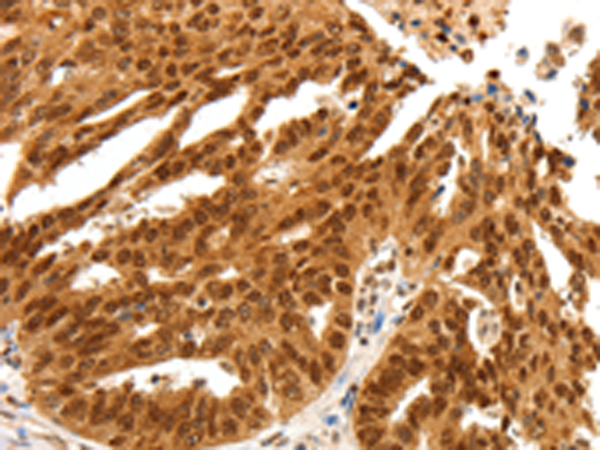

中文名稱: 兔抗PDCD6多克隆抗體
英文名稱: Anti-PDCD6 rabbit polyclonal antibody
別 名: ALG-2, PEF1B
抗 原: PDCD6
儲(chǔ) 存: 冷凍(-20℃)
宿 主: Rabbit
相關(guān)類別: 一抗
反應(yīng)種屬: Human, Mouse
標(biāo) 記 物: Unconjugate
克隆類型: rabbit polyclonal
技術(shù)規(guī)格
|
Background: |
This gene encodes a calcium-binding protein belonging to the penta-EF-hand protein family. Calcium binding is important for homodimerization and for conformational changes required for binding to other protein partners. This gene product participates in T cell receptor-, Fas-, and glucocorticoid-induced programmed cell death. In mice deficient for this gene product, however, apoptosis was not blocked suggesting this gene product is functionally redundant. Alternatively spliced transcript variants encoding multiple isoforms have been observed for this gene, and a pseudogene of this gene is also located on the short arm of chromosome 5. |
|
Applications: |
ELISA, WB, IHC |
|
Name of antibody: |
PDCD6 |
|
Immunogen: |
Fusion protein of human PDCD6 |
|
Full name: |
programmed cell death 6 |
|
Synonyms: |
ALG-2, PEF1B |
|
SwissProt: |
O75340 |
|
ELISA Recommended dilution: |
1000-5000 |
|
IHC positive control: |
Human ovarian cancer and human colon cancer |
|
IHC Recommend dilution: |
25-100 |
|
WB Predicted band size: |
22 kDa |
|
WB Positive control: |
Jurkat and hela cells |
|
WB Recommended dilution: |
200-1000 |

購物車
幫助
021-54845833/15800441009
